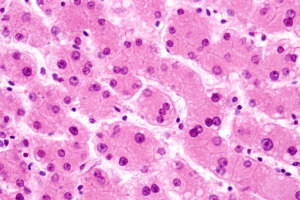
Hepatic Metabolic Effects of Perfluorohexyloctane (F6H8): An Untargeted Metabolomic and Lipidomic Study

Medical licensing is seen as a routine administrative requirement. For today’s physician, nurse practitioner, and physician assistants, licensing is a strategic career tool. Competitive intelligence (CI), the practice of analyzing market trends, competitor behavior, and regulatory data, gives clinicians the insight they need to make informed licensing decisions. Whether planning multi-state expansion, exploring the locum tenens opportunity, or positioning yourself for long-term career growth, CI helps to clarify where to invest your time and resources. This article explores how CI increases licensing from procedural tasks to strategic advantages.
medtigo Medical Licensing Services Â
What Competitive Intelligence Means for Medical Licensing
CI in licensing goes beyond checking state requirements. It includes gathering strategic insights about:
- State medical board trends
- Competitor practice locations
- Payer network saturation and reimbursement dynamics
Basic licensing research, which focuses on documents, timelines, and fees, CI examines the bigger picture:
- Where are other clinicians establishing themselves? Which markets are oversaturated
- Which states offer the highest opportunities for growth, reimbursement, or telehealth expansion?
- When it is used correctly, CI becomes the backbone of smarter, data-driven licensing decisions.
Medical Licensing Requirements by State Â
Key Data Sources for Licensing Competitive Intelligence
Healthcare professionals can gather CI from a combination of private and public resources.
Public Data Sources
FSMB (Federation of State Medical Boards) reports
State medical board dashboards
NPDB (National Practitioner Data Bank) exclusion and disciplinary data
Public reimbursement statistics
Private Intelligence Sources
Payer directories and network participation data
Hospital privilege lists
Locum tenens agency demand trends
Recruitment marketplace insights
Tools for CI
Licensing analytics platforms
Healthcare market research aggregators
Automated monitoring dashboards
These sources create a powerful picture of the licensing landscape in states.
Practical CI Applications in Licensing Strategy
CI transforms licensing into a targeted business strategy. Here is how healthcare professionals use CI in real practice:
1. Market Saturation Analysis
Detect underserved or high-demand states before expanding your practice.
2. Competitor Benchmarking
Analyze where peers and top clinicians’ licenses to uncover the networking or clinical opportunity.
3. Payer Network Intelligence
Choose states with strong reimbursement potential for your specialty.
4. Regulatory Forecasting
Use policy drafts, board meeting minutes, and legislative notices to anticipate upcoming licensing changes.
How Licensing Relies on Credentialing Â
Building Your Licensing CI Framework
A structured CI method makes sure your licensing decisions stay aligned with your long-term professional goals.
Step 1: Define Your Licensing Goals
Are you seeking geographic expansion, locum flexibility, telehealth coverage, or competitive positioning?
Step 2: Set Up Ongoing Data Monitoring
Use alerts, dashboards, board meeting trackers, and payer updates to stay ahead of changes.
Step 3: Conduct Quarterly Strategy Reviews
Reassess your licensing map every 3 months by using updated CI insights to refine your approach.
Subtle Promotion:
Medtigo provides market insights during licensing consultations to help clinicians choose the most advantageous states.
Case Studies: CI-Driven Licensing Success
Case 1: NP Targeting High-Reimbursement States
A nurse practitioner used payer network reimbursement data to secure licenses in the state, offering premium compensation for her specialty and increasing annual earnings significantly.
Case 2: Physician Avoiding Oversaturated Urban Markets
Locum tenens of intelligence helped a physician avoid congested metropolitan areas and instead pursue high-demand rural placements.
Case 3: Telehealth Expansion via Regulatory CI
A multi-state telehealth provider relied on regulatory trend analysis to prioritize states with favorable and stable telemedicine policies.
Conclusion
CI shifts medical licensing from bureaucratic requirements to a strategic competitive asset. Healthcare professionals can expand markets, avoid saturated markets, and position themselves for maximum clinical and financial impact.
Optimize your licensing strategy with medtigo’s expert guidance, where smart insights meet seamless execution.
FAQs
1. How do I access competitor licensing data legally and ethically?
Competitor data is gathered from public state board listings, hospital privilege rosters, payer directories, and regulatory reports without accessing any confidential information.
2. What free tools provide state-by-state licensing market intelligence?
FSMB, state medical board dashboards, CME provider reports, and government healthcare utilization databases offer valuable insights.
3. How often should healthcare professionals update their licensing CI analysis?
Quarterly reviews are ideal, but high-growth specialties may benefit from monthly updates.
4. Can CI help predict which states will tighten licensing requirements?
Yes, board meeting minutes, proposed legislation, and regulatory trend tracking frequently signal upcoming changes.
5. Does Medtigo provide competitive market analysis during licensing applications?
Yes, Medtigo includes CI-based market insights as a value-added service during licensing consultations.